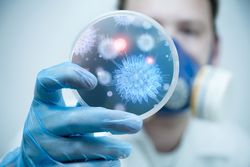

先端テック企業に聞く2025年までに世界を変える17の方法|後編

戦時の写真をAIとカラー化 東大教授と学生が紡ぐ「記憶の解凍」

MacがiPhoneみたいに使いやすく。新macOSパブリックベータ試用レビュー

イスラエルの「データアナリティクス企業」Exploriumが33億円調達

先端テック企業に聞く2025年までに世界を変える17の方法|前編

ヴァージン・ギャラクティック、2021年Q1にも宇宙旅行実現へ

ソニー「VISION-S」試乗体験 これぞ新時代のEVかもしれない

TikTokを米国で猛追する動画アプリがまたもや中国製という現実

インスタが「コピーの寄せ集めアプリ」に FBの戦略に見える限界

ヴァージンがマッハ3の超音速機開発 コンコルドの雪辱なるか